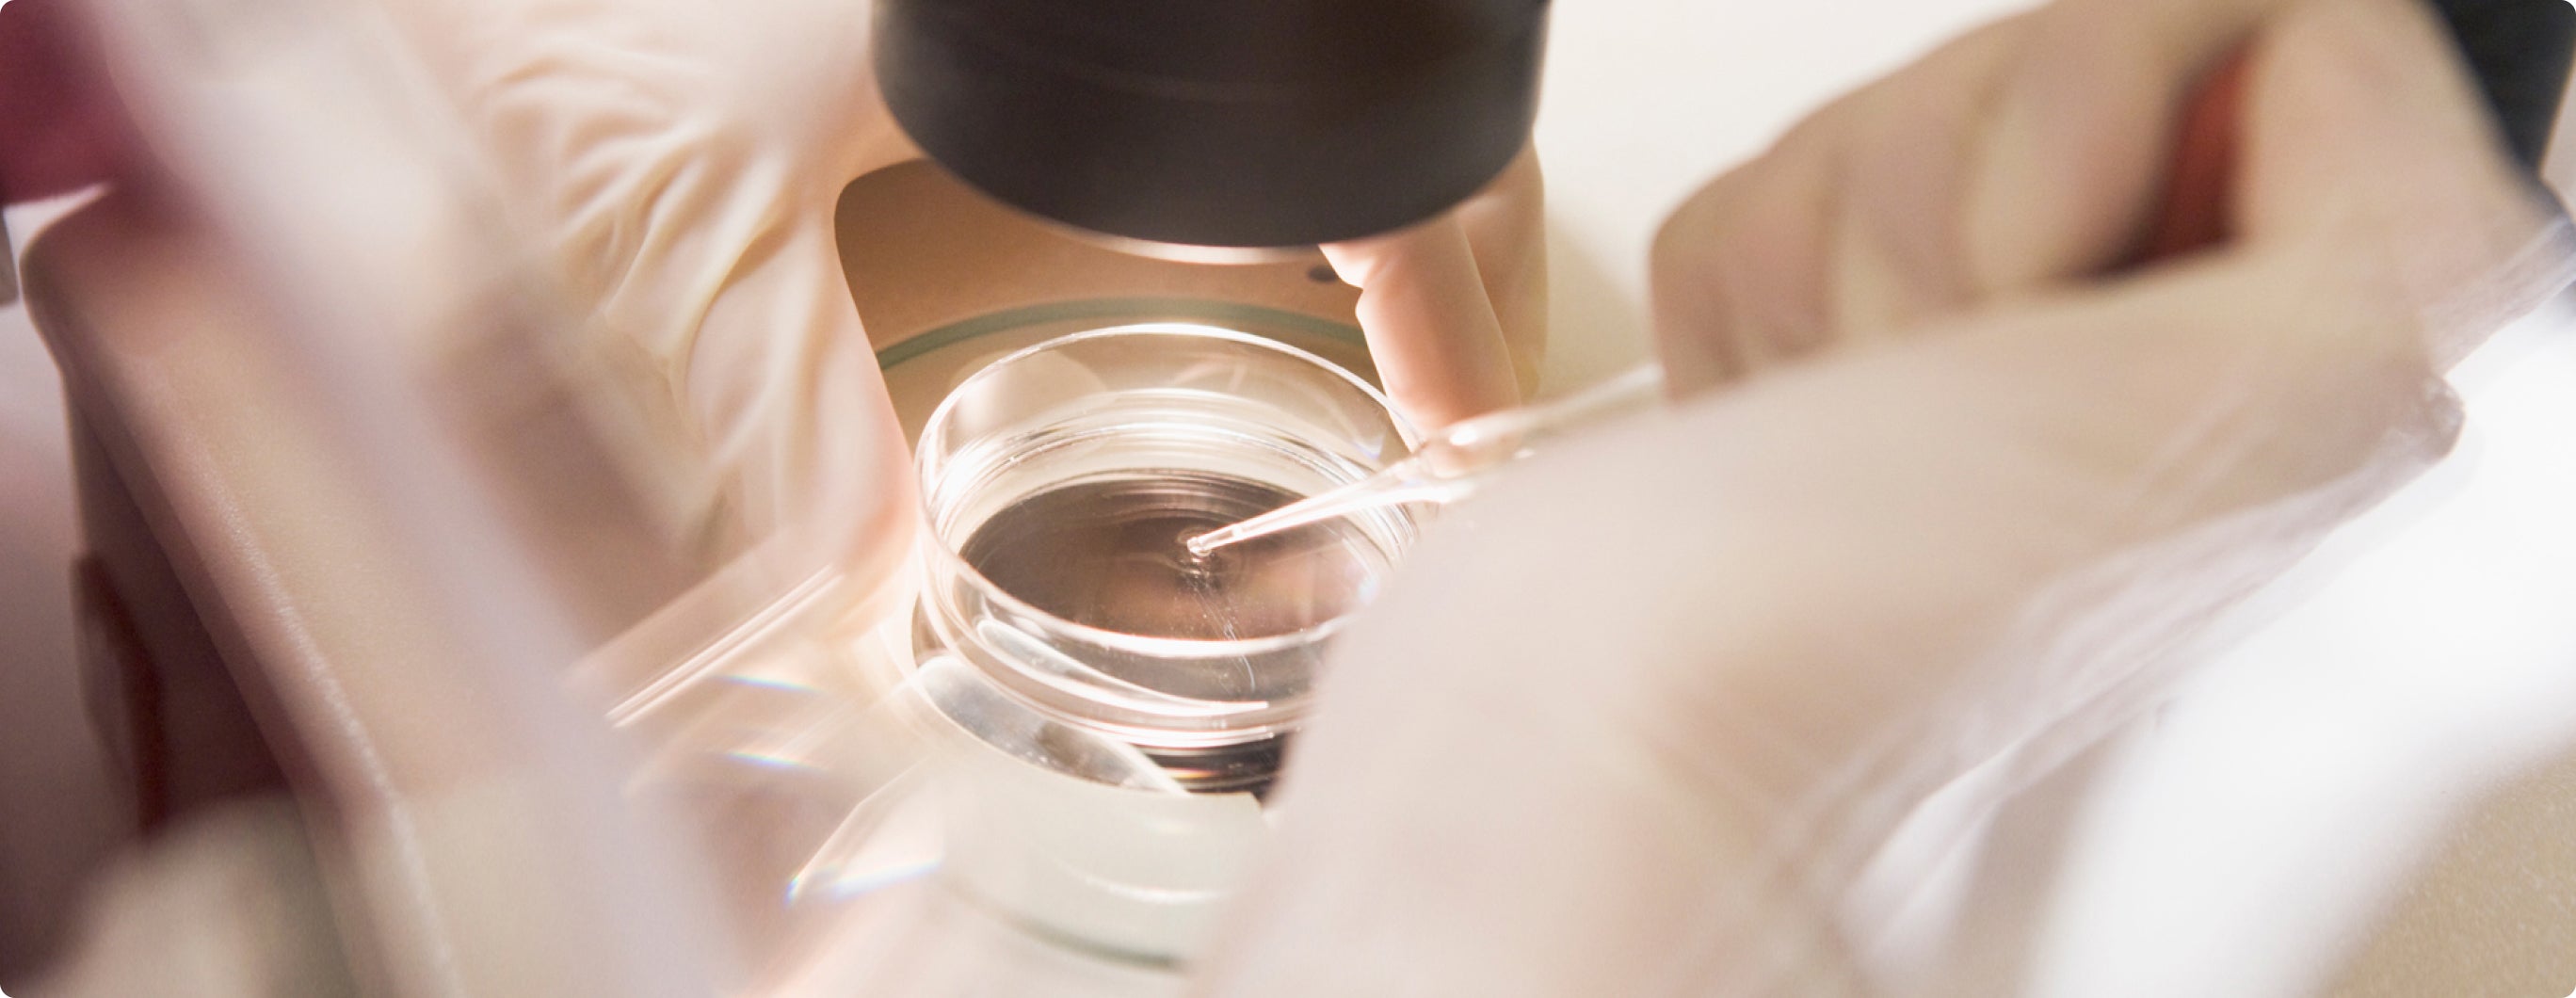

Skin care is a Korean family tradition as deep-rooted as the tea ritual or hanbok.
When a Korean mother teaches her children the importance of keeping their skin clean and hydrated, or protecting themselves from the sun, she is passing on ancient knowledge. More like a way of seeing life. To protect and make it last, rather than to hide.

The secret of Korean beauty
건강함과 아름다움을 추구하는 세라마인은 자연에서 오는 가장 안전하고 자연스러운 제품을 만들어 내는 브랜드 입니다
The Korean skincare tradition reaches Europe. Through a rigorous patented extraction technique, Ceramine obtains the ingredients for its products in an enhanced and environmentally friendly way.

우리에 대해
Technology
Cutting-edge research defines CERAMINE. The professionals at the Ahnjin Bio laboratory, specialized in the development of our products, are responsible for ensuring that our brand protects the skin from pollution and smog with high effectiveness. This happens thanks to the fact that we manage to extract the most powerful natural energy from each of our ingredients.
Instead of using chemicals to extract raw materials, at CERAMINE we use our patented technology to keep the origins of our ingredients alive. In this way, the enzymes we obtain are in a pure state and highly concentrated.
Thanks to this process, these raw materials manage to promote the development of collagen, skin fibroblasts and transepidermal hydration, in addition to reducing inflammation.
About nanoceramides
Ceramides are a yeast fermentation extract that regenerate skin cells and help restore damaged skin. They have anti-inflammatory and moisturizing effects. Compared to other ingredients, they are more stable and have a structure similar to that of human skin, making them a safe and beneficial ingredient for skin care. They are also a great ally in cases of atopic dermatitis and acne, since they increase hydration and strengthen the skin barrier.
CERAMINE products thus focus on the regeneration of skin cells and skin immunity. They are regenerating hypoallergenic cosmetics, with nanoceramides of plant origin and without harmful chemical substances.
세라마인은 건강하고 아름다운 피부를 위해 그린등급 비건 화장품을 제공합니다. 우리는 안전하고 자연스러운 제품을 만들어내는 브랜드입니다.

Looking for health and beauty, green rating, vegan cosmetics, safe cosmetics, nature brands. Ceramine offers green grade vegan cosmetics for healthy and beautiful skin. We are a brand that creates safe and natural products